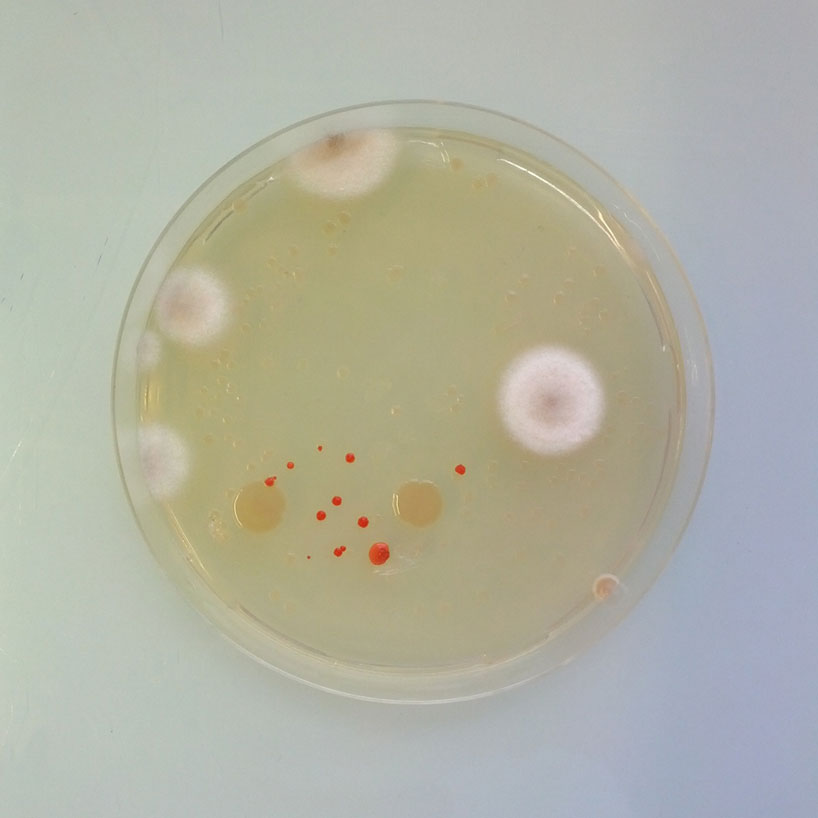
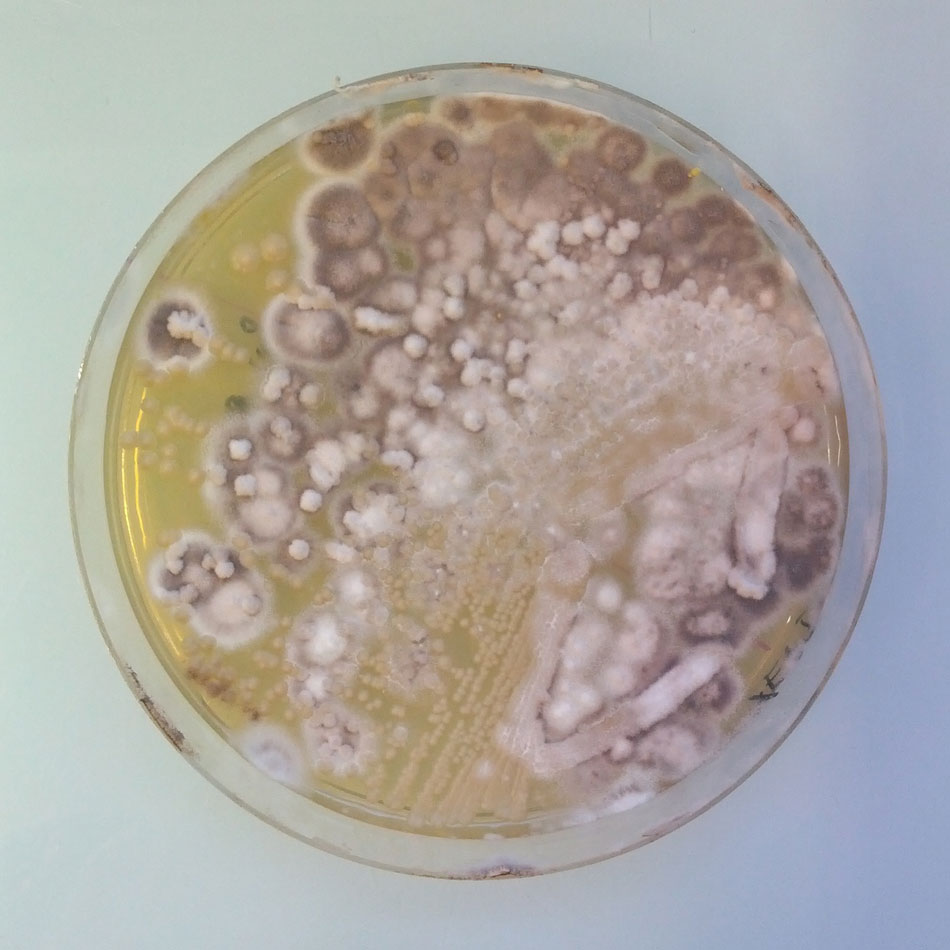
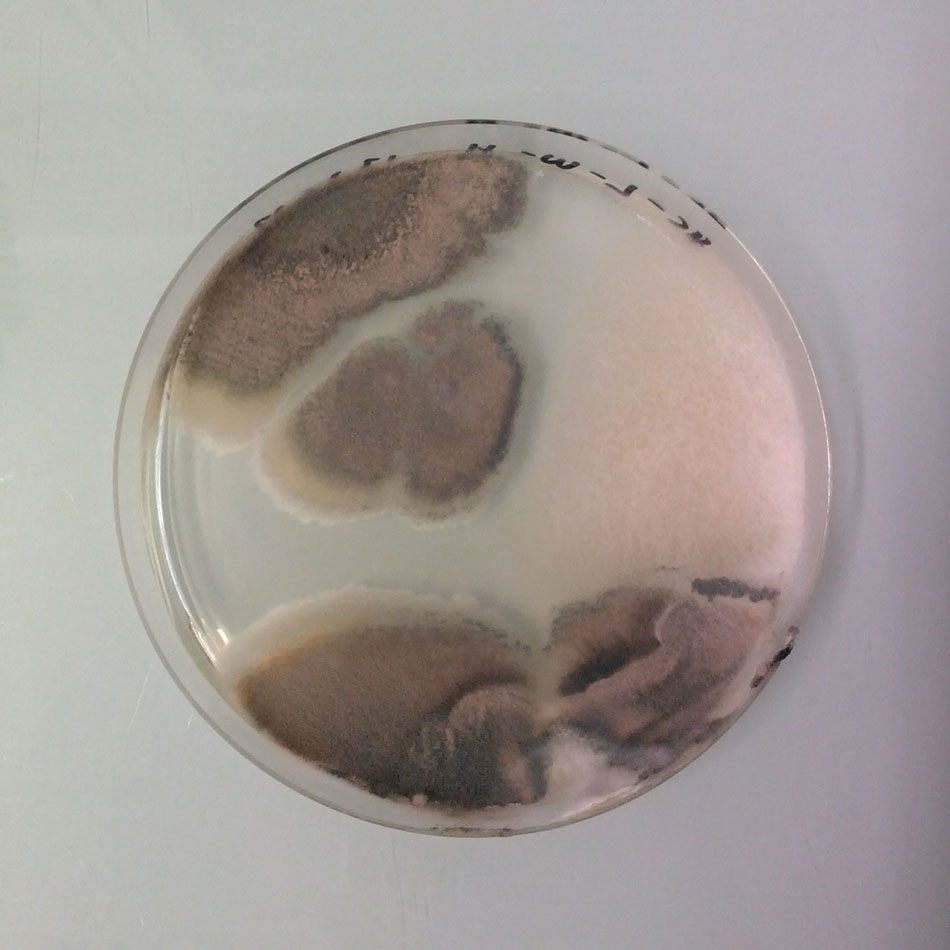
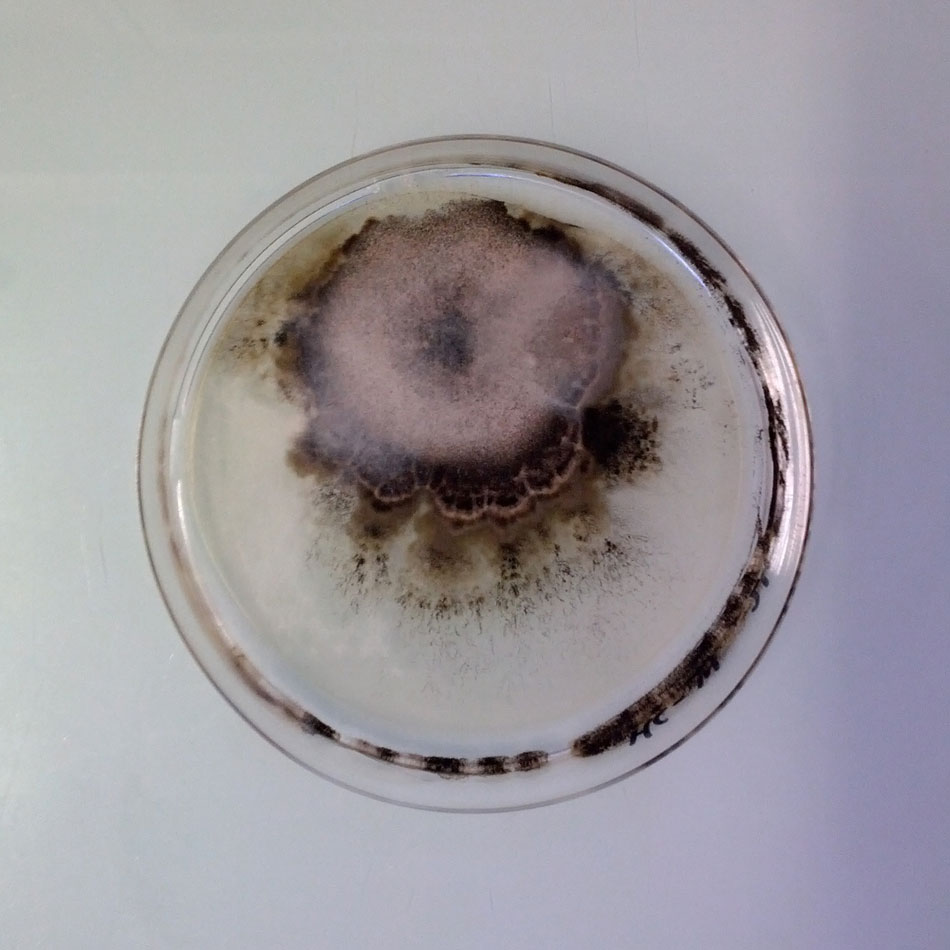
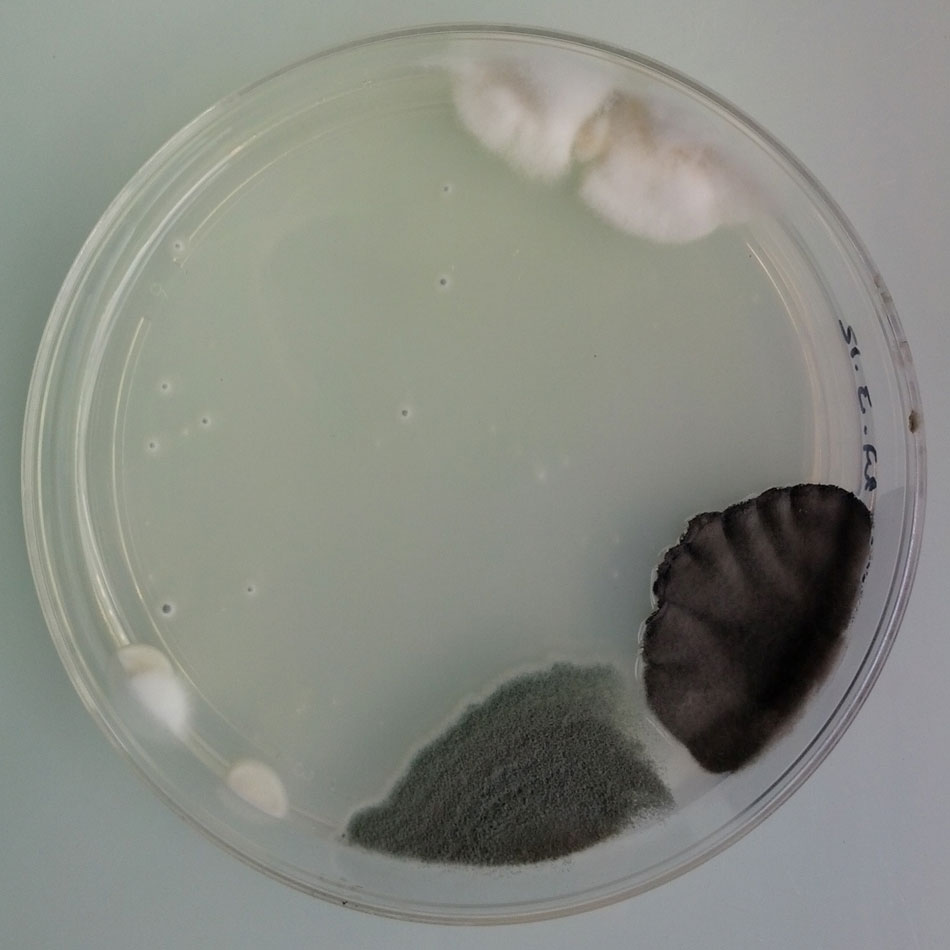
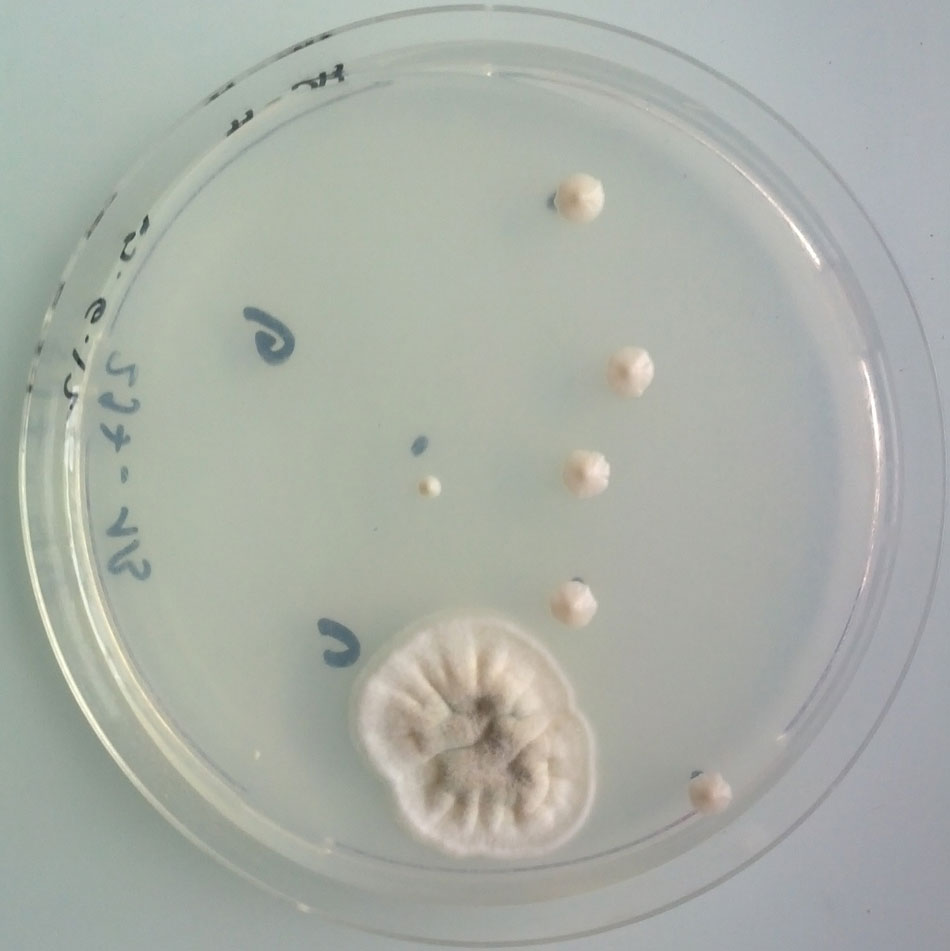
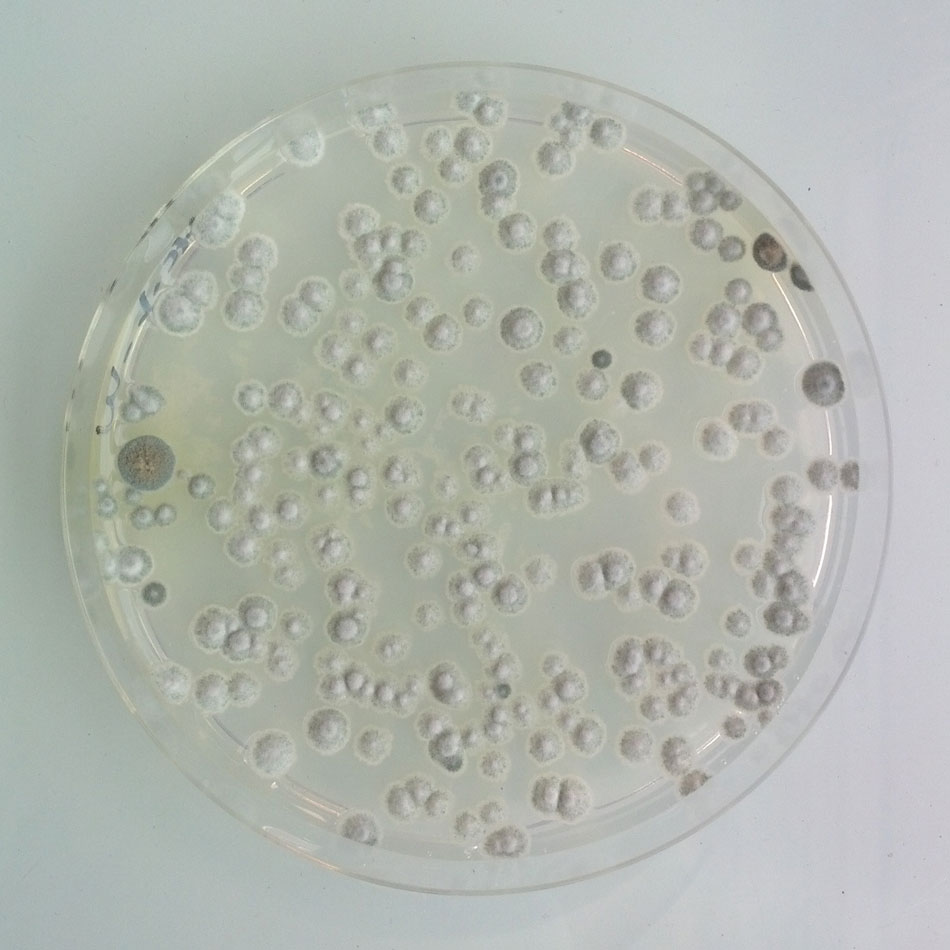

همه ما تجربه برخورد با یک کپک سبز رنگ روی قطعهای نان یا سایر مواد خوردنی را مخصوصا در سنین کودکی به خاطر داریم. به خصوص بار اولی که اعجابمان را برمیانگیخت و جلوتر میرفتیم و دقیقتر میشدیم و از جذابیتها و هندسه و ساختار عجیب این «چیز» عجیب و یکشبه متولد شده در عجب میماندیم. اما متاسفانه مانند سایر چیزهای این دنیا کمی که بزرگ میشویم به کل همه چیز برایمان عادی میشود....
کمتر کسی مثلا به کپک به عنوان یک اثر هنری یا چیز زیبای دوستداشتنی نگاه میکند. کپکها همیشه تناظر معنایی روشنی با آلودگی داشتهاند و آلودگی در مقابل پاکی و زیبایی. اما آنتوان بریدیر ناهمیاس چنین کرده است. او با انتشار تصاویری عجیب از کپکهای کشتشده به دست او در آزمایشگاه، زیبایی این آلودگی قدیمی را به چشم ما آورده است. آلودگی جادویی.